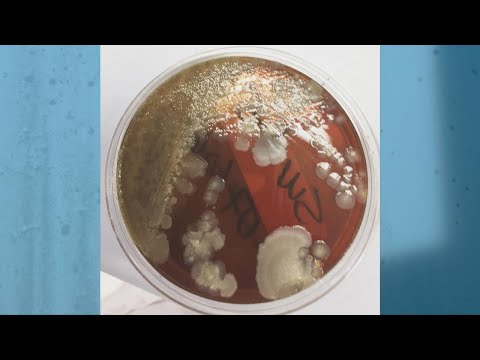

We’d like to remind Forumites to please avoid political debate on the Forum.
This is to keep it a safe and useful space for MoneySaving discussions. Threads that are – or become – political in nature may be removed in line with the Forum’s rules. Thank you for your understanding.
PLEASE READ BEFORE POSTING
Hello Forumites! However well-intentioned, for the safety of other users we ask that you refrain from seeking or offering medical advice. This includes recommendations for medicines, procedures or over-the-counter remedies. Posts or threads found to be in breach of this rule will be removed.📨 Have you signed up to the Forum's new Email Digest yet? Get a selection of trending threads sent straight to your inbox daily, weekly or monthly!
The Prepping Thread - A Newer Beginning ;)
Comments
-
My offspring have now decided to stock up. DD has been to mr.t, says the shelves weren't that full. DH reports that there's no shortage of hand sanitizer but there is a shortage of plastic bottles to put it in. Bar soap it is then.Spend less now, work less later.9
-
It makes sense to have some bottled water in your stores just in case there is disruption to the supply because there is a problem with the infrastructure, water mains do burst, contaminants do get into the reservoirs, or in case enough people who work in the treatment works are off ill to mean they can't ensure the supply is safe to drink from the tap. Given the weather we've had lately and the flooding etc. some bottled water for that type of happening seems quite sensible too doesn't it?11
-
Thanks I shall try to get some bottles tomorrow and store them away. Need to work out whats a reasonable amount for a week at least , washing, drinking etc
“You’re only here for a short visit.
Don’t hurry, don't worry and be sure to smell the flowers along the way.”Walter Hagen
365 Day 1p Challenge for 2021 #41 ✅
Jar £440.31/£667.95 and Bank £389.67/£667.9510 -
tboo said:Thanks I shall try to get some bottles tomorrow and store them away. Need to work out whats a reasonable amount for a week at least , washing, drinking etc
 It might be more economical and efficient to go to a camping store (there are several large national chains) and buy sturdy plastic water carriers. I think the 10 litre models are the best bet, being relatively easy to lift and to store. I do have a couple of 25 litre models but am finding them hard to handle. They will last for many years, and are portable, should one ever have to go to a stand-tap on the street, they're far stronger than water bottles from the SM. Given two or three refills from the tap, they'd pay for themselves.If money is very tight, and you have 2 litre pop bottles, these can easily be rewashed and repurposed.Whatever kind of container you use should be stored away from heat and direct sunlight, to prevent algal growth - chuck a cloth over them if necessary - mine are behind the back of the sofa where there's a gap because the sofa back is at a slight angle. Outta sight but easily accessible if needed. HTH.
It might be more economical and efficient to go to a camping store (there are several large national chains) and buy sturdy plastic water carriers. I think the 10 litre models are the best bet, being relatively easy to lift and to store. I do have a couple of 25 litre models but am finding them hard to handle. They will last for many years, and are portable, should one ever have to go to a stand-tap on the street, they're far stronger than water bottles from the SM. Given two or three refills from the tap, they'd pay for themselves.If money is very tight, and you have 2 litre pop bottles, these can easily be rewashed and repurposed.Whatever kind of container you use should be stored away from heat and direct sunlight, to prevent algal growth - chuck a cloth over them if necessary - mine are behind the back of the sofa where there's a gap because the sofa back is at a slight angle. Outta sight but easily accessible if needed. HTH.
Every increased possession loads us with a new weariness.
John Ruskin
Veni, vidi, eradici
(I came, I saw, I kondo'd)
14 -
I have just purchased 4 x 25l water carriers off Amaz0n, £23.99, nearest camping store was a bit away so seemed best optionWhen full will store them in the understairs cupboard“You’re only here for a short visit.
Don’t hurry, don't worry and be sure to smell the flowers along the way.”Walter Hagen
365 Day 1p Challenge for 2021 #41 ✅
Jar £440.31/£667.95 and Bank £389.67/£667.9511 -
make a note to yourself to change the water every three months.It doesn't matter if you are a glass half full or half empty sort of person. Keep it topped up! Cheers!13
-
tboo said:I have just purchased 4 x 25l water carriers off Amaz0n, £23.99, nearest camping store was a bit away so seemed best optionWhen full will store them in the understairs cupboardA word to the wise; weight.1 litre of water weighs 1 kilo aka 2.5=2 lb.25 litres = 55lb4 x 55 lb = 220 lb or 15 and a half stones. Depending on the cupboard floor, and the joists, that could well be a problem. I would be tempted to keep them downstairs, ideally on a concrete sub-floor.If you ever have to store plastic containers on naked concrete, please be aware it causes plastic to rot and fail over time. Which is why my plastic water barrels on the allotment patio are actually sitting up on sections of fencepost wood, rather than just on the concrete slabs. HTH
Every increased possession loads us with a new weariness.
John Ruskin
Veni, vidi, eradici
(I came, I saw, I kondo'd)
12 -
annieb64 said:I work in a charity shop a couple of days a week. There's only one toilet with a towel for hand drying so I'm wondering if I should take my own small towel rather than use the communal one.Having had a bad chest infection earlier this year I really don't want to risk catching anything else.No don't use a towel at all, use disposable paper towels, Is it open to the public? or more than 2 people?1: Can you be 100% sure only you would use it.2: Can you be sure they even wash correctly and arnt just wiping the virus on the towel.3: can you be 100% sure everyone closes the lid when flushing.Sky news
7 -
Oh I've been buying a few large bottles form Tescos. I didn't realise you could store tap water for that long - good to know.maryb said:make a note to yourself to change the water every three months.
10 -
One thing I’d suggest stocking up on in case of a quarantine is vitamin D supplements. You’re supposed to take them over winter anyway, but you should definitely be taking some if you’re not allowed outdoors and exposed to the sun at all for two weeks.Original mortgage free date: November 2044Current mortgage free date: November 2038Chipping away...10
This discussion has been closed.
Confirm your email address to Create Threads and Reply

Categories
- All Categories
- 354.9K Banking & Borrowing
- 254.6K Reduce Debt & Boost Income
- 455.7K Spending & Discounts
- 247.7K Work, Benefits & Business
- 604.7K Mortgages, Homes & Bills
- 178.7K Life & Family
- 262.3K Travel & Transport
- 1.5M Hobbies & Leisure
- 16.1K Discuss & Feedback
- 37.7K Read-Only Boards







 https://www.youtube.com/watch?v=1pFww_EaLiY
https://www.youtube.com/watch?v=1pFww_EaLiY https://www.youtube.com/watch?v=DDc7-oya1Qg
https://www.youtube.com/watch?v=DDc7-oya1Qg https://www.youtube.com/watch?v=ejl7vrDUIcs
https://www.youtube.com/watch?v=ejl7vrDUIcs https://www.youtube.com/watch?v=XAclQsqvIKo
https://www.youtube.com/watch?v=XAclQsqvIKo https://www.youtube.com/watch?v=mJ3BE9sGm5w
https://www.youtube.com/watch?v=mJ3BE9sGm5w
